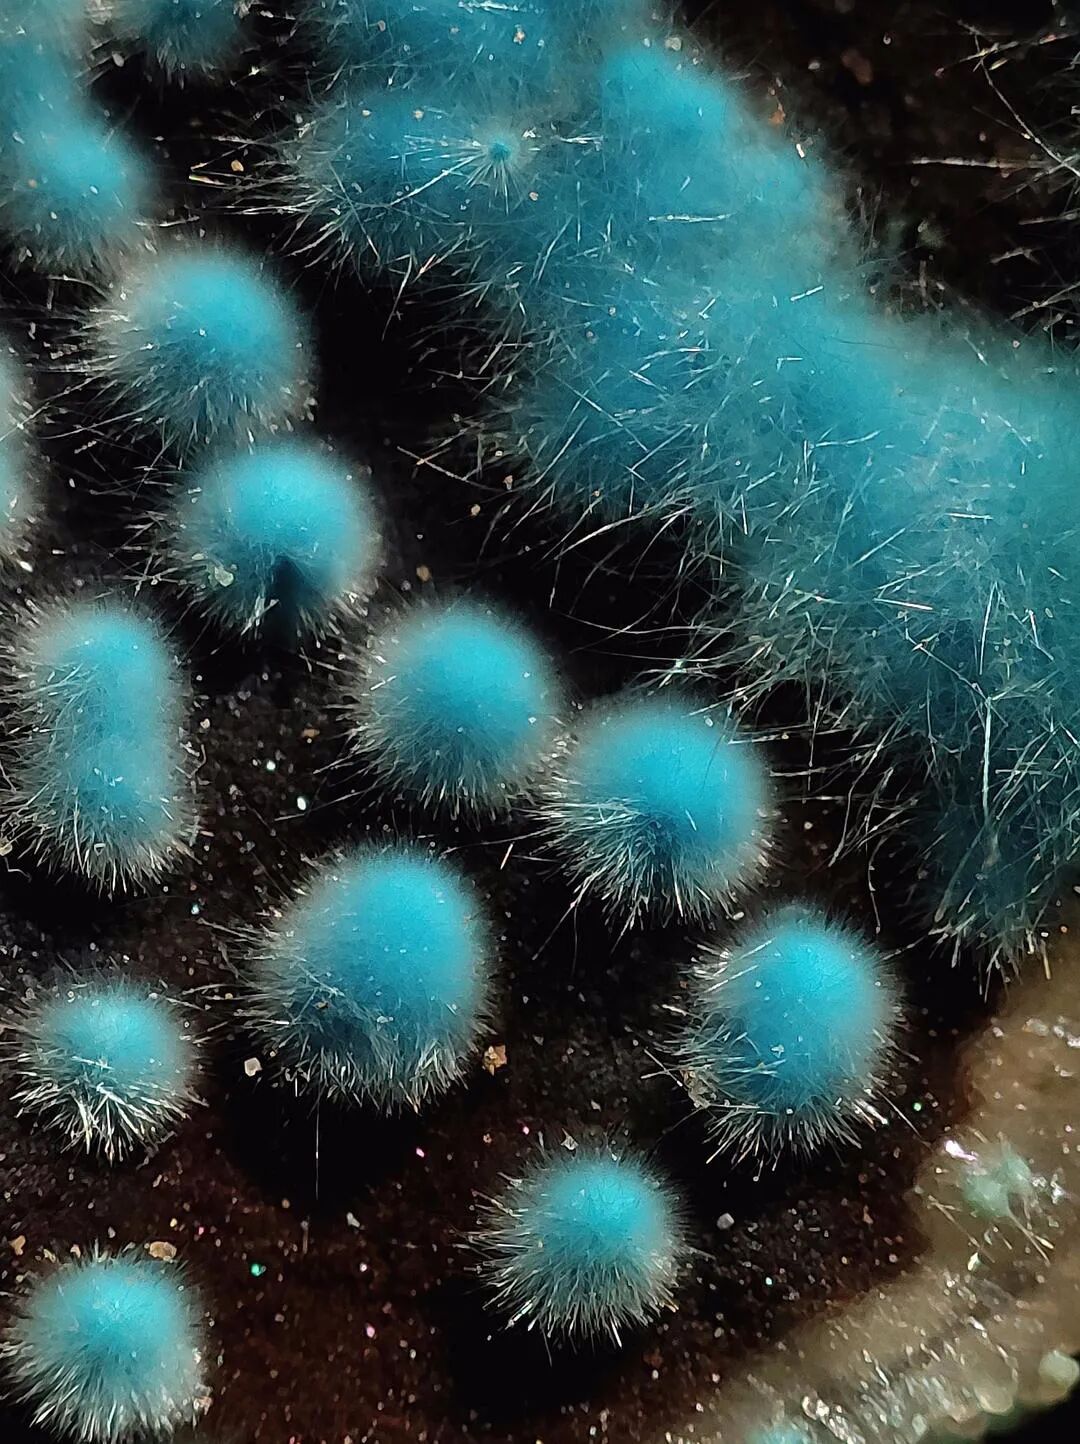

这里是“广播精选”栏目,每周日早8点更新,不见不散哦~
我妈收藏了两箱82年的肥皂, 开箱之前我先在网上查了一下会不会释放毒气,他们都说没事。 明天打算用一块 来自豆瓣话题#爸妈的天才创造#

朋友买了个吸烟角放家里😅

昨天在一家很小的餐厅和朋友吃饭,桌与桌之间离得特别近。 邻桌的一对年轻男女明显是在相亲,双方努力抛出一个又一个话题,不幸每个话题上都找不到共同点,气氛微妙而尴尬。 直到男生提起去年看过的一个展览,女生正好也看过,两个人终于在一瞬间迸发了心有灵犀的共鸣: “啊那个展真是太令人失望了对吧!”“是啊,做得好差!谁要来看这些啊!”“字还那么多!”“真的是!……” 气氛骤然热烈起来。 而我和朋友面面相觑----显然他们并不知道,这个展览的两位策展人员就坐在他们旁边。 (不知为什么感觉还挺开心的!大概就是所谓存在感吧) 来自豆瓣话题#那些因为机缘巧合而发生的尴尬事件#
高中美术老师,我一直觉得他就是所谓的“有趣的灵魂”,他的课也一直超受欢迎 来自豆瓣话题#老师的有趣的头像或者朋友圈#


最近在公共厕所做了自己的第一个独立策展,所有家人都不理解的情况下,外公外婆来现场支持,真的很感动。 来自豆瓣话题#看展记#







身后就是未来 来自豆瓣话题#在地铁上,除了看手机还有哪些选择#

无人驾驶地铁的诱惑,小朋友哪里抵得住 来自豆瓣话题#地铁观察日记#

这个我可一定要发言了,在公交车上,每个女孩子都有一件羊羔绒哈哈哈哈哈 来自豆瓣话题#奇奇怪怪撞衫大赏#

嗦完小面 发现老板上墙贴广告去了👍👍 来自豆瓣话题#你用手机拍过哪些有故事感的画面?#

我爸已经沦陷了,我妈还在思考 来自豆瓣话题#父母养宠物后#



这两只吧 来自豆瓣话题#那些瞬间让你真切感受到了生活的有趣#


这表情可以说是一模一样了 西安碑林猫:白昼

来自豆瓣话题#日常生活用品的另类用途#


拍蔬菜玩儿,然后吃进肚子里 来自豆瓣话题#我培养的低成本爱好#







我的小玻璃拼在一起 就有了专属于我的光~





我拥有一件世界名画 每天背着世界名画出门,惴惴不安!! 但是仍然想和你们分享她的可爱吖~ 来自豆瓣小组“可爱事物分享”



英语里有一个单词,Pluviophile,指的是一看到下雨就心情平静,或者本身喜欢淋雨的人。我特别迷恋这种昏暗的,清冷的,湿润中雾气朦胧,安静中暗流汹涌的意象。 来自豆瓣话题#你有哪些不为人知的癖好?#



昨晚上和几个狐朋狗友喝酒,庆祝我写了篇论文得了些钱。喝到半途,女生因为恋情的纠葛走了,吐了的男生也跟着自己对象离开。一个人提议说今晚上不睡觉了,大家都爽快答应,这种感觉真的很棒。店开到三点,但刚转钟,几个图谋不轨的男的就逼得我们不得不离开。于是去海底捞,我也不记得我吃了什么东西。 朋友提议说去看长江,大家又都很爽快的答应,于是毫不犹豫地出发,向不知道多远的地方行走。路上唱歌,聊哲学,爱情,还有乱七八糟的胡话。我们两个小时只走了两公里。也不知道走了多久,大家只觉得亢奋但腿却是酸疼的了。于是打车,一个闻起来也满身酒味的师傅带我们到了长江大桥边,对我们说如果下雨了可以在桥下躲雨。这句话很是触动我,他也年轻过,他理解。 凌晨的长江边,冷的透骨。确实下起了大雨,我们真的到了桥洞下躲雨,我蜷缩在角落,就那样坐着睡着了半个小时。我们说看日出,但是武汉这糟糕的天气什么都看不见,我们只是在等着天亮。 等到手机上显示应该是日出的时刻,我们却在到处找公共厕所。最后才发现,原来我们连日出的方向都搞错了。 噢,还有那两个女生。她们坐在路边,互相揽抱着,仰着头,看根本不存在的星星,或者说是长江大桥肮脏的桥底。但是显得那样好,于是我拿起手机拍了下来。 今天早上,我错过了自己想蹭的课,但看到手机里这张照片时,却觉得值得,而且想到了很多。我一直觉得,年轻人就应该狂妄自大,听摇滚乐,反抗一切东西,不管这样的反抗是不是真的正确。有自己的正义感,不管这正义感是真的还是邪恶。怀疑,不管有时候因为无知而显得愚蠢。年轻人应该是理想主义的,就是要去做这些浪漫而疯狂的事情。 也许明天,她就为了钱沉沦了,明天,我发现自己其实原来是那么平庸。但是直到今天为止,我们都还有光明的未来。
工作10年以后,辞职考雅思,去读了自己想读的学校,去了想去的地方。这是在威尼斯拍的一张照片,世界好精彩,人生也应该这样。 来自豆瓣话题#我为生活预留的gap#

朋友送我的礼物盒里的泡泡纸 越看越喜欢,有点不舍得扔了 来自豆瓣小组“无用美学”

碳绒铜矿 🧫 产地:贵州晴隆大厂
我妈昨天在树旁呆了一下午,领雀嘴鹎吃樱桃🍒 来自豆瓣话题#与动物的一次奇妙相遇#







《恋人》 来自豆瓣话题#你用手机拍过哪些有故事感的画面?#

牵手的人越来越多了👫👭👬👨👩👦 来自豆瓣话题#你所在的城市春天是怎样的?#



春天是阶梯 Sony A7R2 腾龙28-75 布里斯托大学艺术学院 来自豆瓣话题#2021豆瓣春季摄影大赛#



在澳洲一个公园拍的阶梯 向下的,感觉很神秘,像纳尼亚传奇里打开衣柜会看到新世界一样。 来自豆瓣小组“阶梯爱好者”

阳光把生活变成了琴键~ 来自豆瓣话题#你抓拍的街头巧合#

月亮路灯🌙 仰视视角,路灯好像一轮月亮哇。 来自豆瓣小组“无用美学”

偷走了一窗的花 今天上班路上看到一辆偷走了一窗花的车,尽力偷拍了! 来自豆瓣小组“无用美学”


意外之美|春江水暖鸭先知 鸭子应该是游不动了 来自豆瓣小组“无用美学”




可以穿短袖爬岳麓山的时刻~ 来自豆瓣话题#夏天开始的瞬间#

开会、乏味的灰色星期一,特别想念前一个周末的海边下午茶——自己拍下第一张照片的时候都觉得色彩特别清爽舒服,有种夏天已至的心情。 啊,我真喜欢夏天。 来自豆瓣话题#你生活中cozy的时刻#




去西岸爬了个巨大建筑(偷偷地 有种偷偷过夏天的感觉 来自豆瓣话题#夏天开始的瞬间#








去年夏天的晚霞存货 原图直出 晚霞太美了! 来自豆瓣小组“无用美学”


樱 来自豆瓣话题#2021豆瓣春季摄影大赛#

2012年,我和十几位朋友在上海做过一个1812年博罗蒂诺战役的沙盘,一转眼也快10年啦。彼时的那份得意从未忘却,而过去十年里遭遇艰难的时刻,心里也常有老柴1812序曲的伴奏,遇到特别窒息的环境和事,还会有习惯在心里对自己说:想想人家博尔孔斯基亲王! 来自豆瓣话题#用你的玩具拍一张有故事性的照片#









算算玩胶片的时间都超过十年了,但拍过的卷加起来可能还不如别人一年的量(穷+懒)。每次拿起胶片机的时候,拍照总是特别认真,毕竟每张成本还挺高的而且拿着几十年的老相机总觉得不能对不起它,总之学会了珍惜。 也干过很多蠢事,比如满心欢喜期待的拍完发现忘放卷或者盖子没盒好曝光啦,水瓶子没拧紧把相机和胶卷都泡了啦,相机摔故障跑焦缺不知道拍了好多卷糊的啦……想想都是血泪史(被自己蠢哭),很多东西错过了就是错过了。但是当胶片冲扫出来的时候,真的像等着拆礼物的小朋友一样兴奋,尤其当发现有满意的照片的时候,真的一天都被点亮了。 随着年龄渐长,翻看这些胶片的时候,不知道是因为胶片特有的温柔的色调,还是因为当时拍照时的专注,很多回忆闪闪都发光。 能玩胶片真是件很美好很开心的事情。
1-3 冰岛 4-6 英国 7-9 意大利 相机:禄来 2.8F 来自豆瓣话题#豆瓣胶片摄影大赛#









大面积春耕已开始, 也不知道多少年没有看到过这样的景象了。 大概是童年了吧。 来自豆瓣话题#2021豆瓣春季摄影大赛#





那大概就是我自己了吧,云南山里住了4年后,去年因为一些际遇入了道门,现在暂住在某道观修道 来自豆瓣话题#你生活中具有武侠江湖氛围的场景#









今天学到了一个“一摸就炸”的植物。
啊哈哈哈哈哈哈哈傻马打呼噜 来自豆瓣话题#视频·记录你的乡村生活#
四月了,空气里有种岩井俊二的气息。弹段《情书》💌插曲 来自豆瓣话题#视频·每天弹段钢琴曲#




